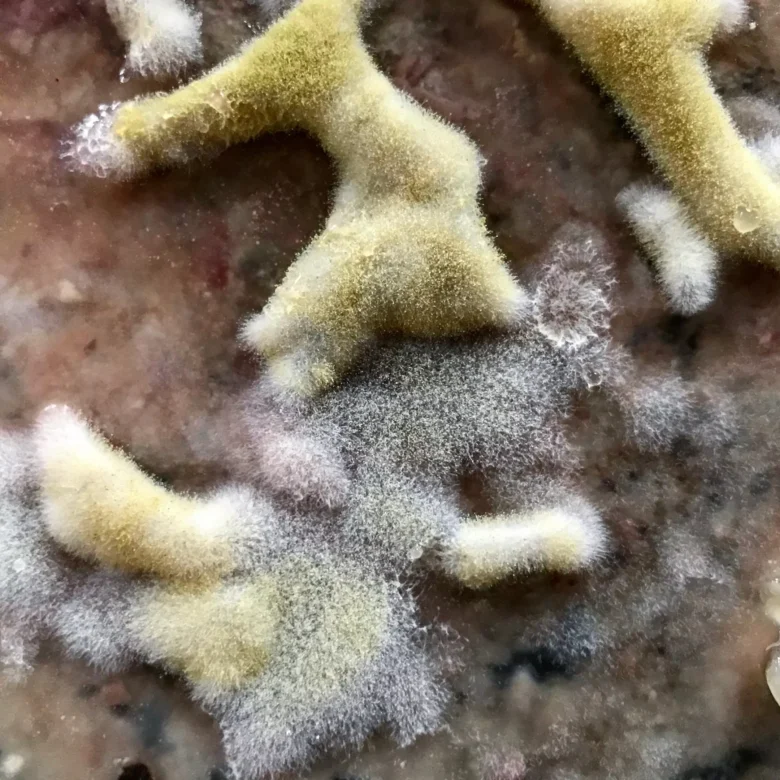

Deprecated: mb_convert_encoding(): Handling HTML entities via mbstring is deprecated; use htmlspecialchars, htmlentities, or mb_encode_numericentity/mb_decode_numericentity instead in /var/www/html/wp-content/plugins/super-cool-ad-inserter/inc/scaip-shortcode-inserter.php on line 37
Usually when the words “mold” and “food” are used together in a sentence, it doesn’t have the tastiest result (well, except in cheese). However, Cleveland chef Jeremy Umansky has been using koji, a mold that has been cultivated in Japan for thousands of years, to add flavor to his foods and cure meats in nearly half the time. Koji is his silent partner in the kitchen.
This article appears in Mar 29 – Apr 4, 2017.